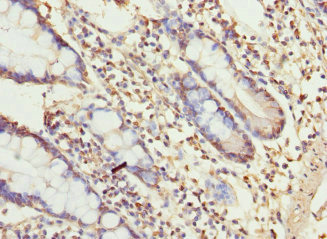

UGT3A2 Antibody
-
中文名稱:UGT3A2兔多克隆抗體
-
貨號:CSB-PA667485ESR2HU
-
規格:¥440
-
圖片:
-
其他:
產品詳情
-
產品名稱:Rabbit anti-Homo sapiens (Human) UGT3A2 Polyclonal antibody
-
Uniprot No.:
-
基因名:UGT3A2
-
別名:EC 2.4.1.17 antibody; MGC119426 antibody; MGC119429 antibody; OTTHUMP00000221219 antibody; UD3A2_HUMAN antibody; UDP glucuronosyltransferase 3A2 antibody; UDP glycosyltransferase 3 family polypeptide A2 antibody; UDP-glucuronosyltransferase 3A2 antibody; UDPGT 3A2 antibody; Ugt3a2 antibody
-
宿主:Rabbit
-
反應種屬:Human
-
免疫原:Recombinant Human UDP-glucuronosyltransferase 3A2 protein (23-300AA)
-
免疫原種屬:Homo sapiens (Human)
-
標記方式:Non-conjugated
-
克隆類型:Polyclonal
-
抗體亞型:IgG
-
純化方式:Antigen Affinity Purified
-
濃度:It differs from different batches. Please contact us to confirm it.
-
保存緩沖液:PBS with 0.02% sodium azide, 50% glycerol, pH7.3.
-
產品提供形式:Liquid
-
應用范圍:ELISA, IHC
-
推薦稀釋比:
Application Recommended Dilution IHC 1:20-1:200 -
Protocols:
-
儲存條件:Upon receipt, store at -20°C or -80°C. Avoid repeated freeze.
-
貨期:Basically, we can dispatch the products out in 1-3 working days after receiving your orders. Delivery time maybe differs from different purchasing way or location, please kindly consult your local distributors for specific delivery time.
-
用途:For Research Use Only. Not for use in diagnostic or therapeutic procedures.
相關產品
靶點詳情
-
功能:UDP-glucuronosyltransferases catalyze phase II biotransformation reactions in which lipophilic substrates are conjugated with glucuronic acid to increase water solubility and enhance excretion. They are of major importance in the conjugation and subsequent elimination of potentially toxic xenobiotics and endogenous compounds.
-
基因功能參考文獻:
- A phenylalanine (Phe-391) in UGT3A2 favors UDP-Glc use. PMID: 22621930
-
亞細胞定位:Membrane; Single-pass type I membrane protein.
-
蛋白家族:UDP-glycosyltransferase family
-
數據庫鏈接:
Most popular with customers
-
YWHAB Recombinant Monoclonal Antibody
Applications: ELISA, WB, IHC, IF, FC
Species Reactivity: Human, Mouse, Rat
-
Phospho-YAP1 (S127) Recombinant Monoclonal Antibody
Applications: ELISA, WB, IHC
Species Reactivity: Human
-
-
-
-
-
-